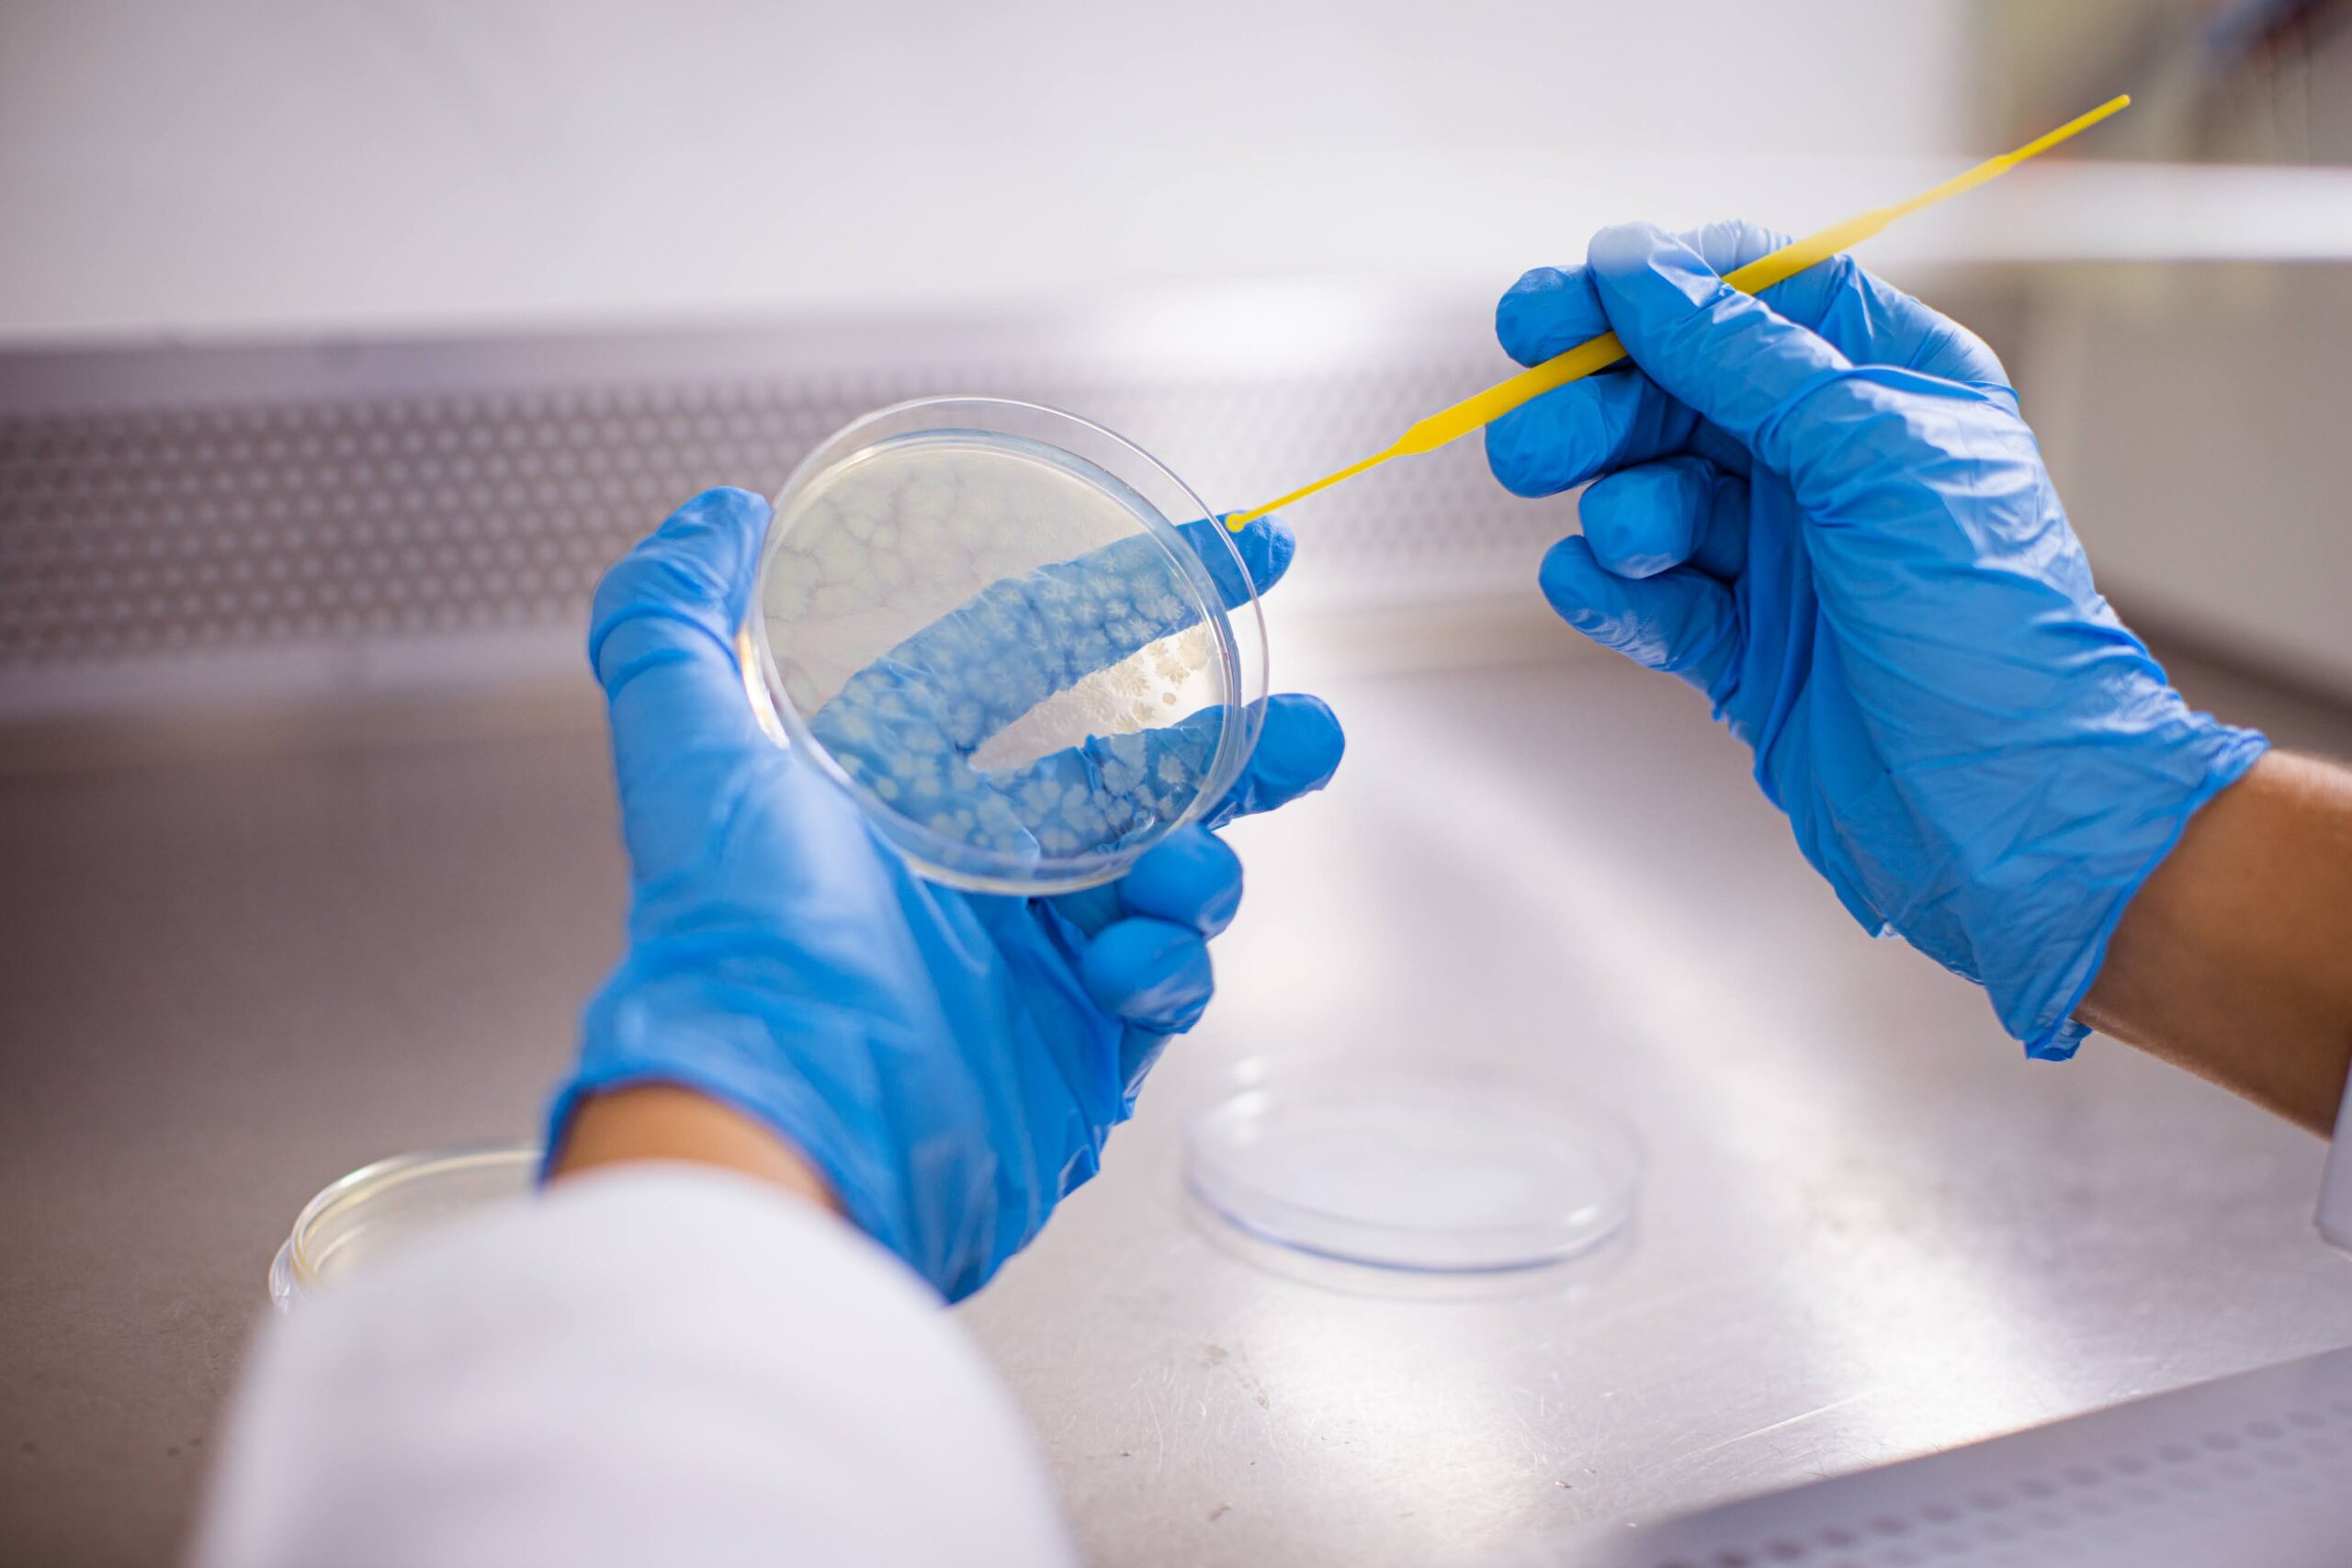

Governo do Amazonas inicia processo de revitalização da exposição ‘Cidade de Santa Anita’ na Galeria do Largo
Iniciativa também vai modernizar e trazer melhorias ao espaço que abriga a exposição permanente, montada no local há 17 anos

Iniciativa também vai modernizar e trazer melhorias ao espaço que abriga a exposição permanente, montada no local há 17 anos

Evento ocorre em Lisboa, em Portugal, até 5 de março e tem expectativa de receber mais de 45 mil visitantes

Procuradoria Judicial da Saúde e Procuradoria Judicial Comum da PGE reuniram com técnicos da SES-AM

Com utilização de aeradores subsidiados pela ADS, produtividade do tambaqui roelo poderá aumentar em até quatro vezes

O HPV é a infecção sexualmente transmissível mais comum no mundo, e pode ocasionar o desenvolvimento do câncer do colo do útero
As chamadas somam mais de R$ 19 milhões de recursos oriundos do tesouro estadual

Em média, vítimas relataram ter sofrido quatro agressões no ano

Exame irá beneficiar aproximadamente 30 pacientes por mês e diminuir tempo de espera para diagnóstico de doenças relacionadas ao sistema nervoso

Seis municípios concentram quase a totalidade do desmatamento registrado na região, com área desmatada equivalente a 160 mil campos de futebol

Facilidade no acesso aos serviços e mutirão contribuíram para elevar índices de produção da Fuham
Receba os principais destaques todos os dias no seu email.
| Cookie | Duração | Descrição |
|---|---|---|
| cookielawinfo-checkbox-analytics | 11 months | This cookie is set by GDPR Cookie Consent plugin. The cookie is used to store the user consent for the cookies in the category "Analytics". |
| cookielawinfo-checkbox-functional | 11 months | The cookie is set by GDPR cookie consent to record the user consent for the cookies in the category "Functional". |
| cookielawinfo-checkbox-necessary | 11 months | This cookie is set by GDPR Cookie Consent plugin. The cookies is used to store the user consent for the cookies in the category "Necessary". |
| cookielawinfo-checkbox-others | 11 months | This cookie is set by GDPR Cookie Consent plugin. The cookie is used to store the user consent for the cookies in the category "Other. |
| cookielawinfo-checkbox-performance | 11 months | This cookie is set by GDPR Cookie Consent plugin. The cookie is used to store the user consent for the cookies in the category "Performance". |
| viewed_cookie_policy | 11 months | The cookie is set by the GDPR Cookie Consent plugin and is used to store whether or not user has consented to the use of cookies. It does not store any personal data. |